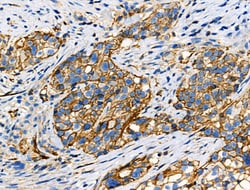
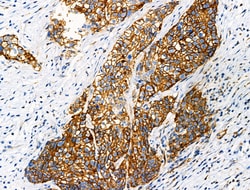

Promotional price valid on web orders only. Your contract pricing may differ. Interested in signing up for a dedicated account number?
Learn More
Learn More
Invitrogen™ Phospho-ITGB1 (Tyr783) Polyclonal Antibody


Rabbit Polyclonal Antibody
Supplier: Invitrogen™ PA5106095
Description
Antibody detects endogenous levels of Integrin beta 1 only when phosphorylated at Tyr783.
CD29, also known as ITGB1 or Integrin Subunit Beta 1, is a 110 kDa cell surface glycoprotein widely expressed by various cells, including all leukocytes. It forms non-covalently linked heterodimers with at least six different alpha integrins (CD49a-f), creating VLA-1 through VLA-6 complexes, as well as with CD51. These alpha-beta integrin heterodimers mediate a range of cellular responses, including adhesion, trafficking, proliferation, and differentiation. CD29-containing integrins bind to extracellular matrix proteins such as collagen, laminin, fibronectin, and vitronectin. Some integrins also interact with cellular receptors like VCAM-1 and MadCAM-1. CD29 plays a crucial role in immune cell trafficking from blood to tissue, particularly during leukocyte emigration and extravascular migration. It is involved in regulating tissue damage and disease symptoms related to inflammatory bowel disease. In the presence of anti-tumor drugs, decreased expression of ITGB1 correlates with multidrug resistance in tumor cells. ITGB1-dependent mechanisms enhance cytokine secretion in human airway smooth muscle in response to IL-1beta, facilitated by fibronectin and type I collagen. More than eight beta subunits with numerous splice variant isoforms have been identified in mammals, including two major forms: beta1A and beta1D. Beta1A is present in all tissues except cardiac and skeletal muscle, which express the beta1D variant.
Specifications
| Phospho-ITGB1 (Tyr783) | |
| Polyclonal | |
| Unconjugated | |
| ITGB1 | |
| 4633401G24Rik; AA409975; AA960159; Beta OL; beta oligodendroglia; CD29; CSAT antigen; ENSMUSG00000051907; Fibronectin receptor subunit beta; FNRB; Glycoprotein IIa; Gm9863; gpIIa; integrin beta 1; integrin beta 1 (fibronectin receptor beta); integrin beta 1A precursor; Integrin beta1; integrin beta-1; integrin beta-1 subunit; integrin beta1D; integrin precursor; integrin subunit beta 1; integrin VLA-4 beta subunit; integrin VLA-4 subunit beta; integrin, beta 1; integrin, beta 1 (fibronectin receptor, beta polypeptide, antigen CD29 includes MDF2, MSK12); ITBG1D; ITGB1; JG22 antigen; MDF2; MSK12; RGD-receptor; very late activation protein, beta polypeptide; VLA-4 subunit beta; VLAB; VLA-BETA | |
| Rabbit | |
| Sequential chromatography | |
| RUO | |
| 16412, 24511, 3688 | |
| -20°C | |
| Liquid |
| Immunohistochemistry (Paraffin), Western Blot, Immunocytochemistry | |
| 1 mg/mL | |
| PBS with 50% glycerol and 0.02% sodium azide; pH 7.4 | |
| P05556, P09055, P49134 | |
| ITGB1 | |
| A synthesized peptide derived from human ITGB1(Accession P05556), corresponding to amino acid residues around phosphorylated Tyr783. | |
| 100 μL | |
| Primary | |
| Human, Mouse, Rat | |
| Antibody | |
| IgG |
Product Content Correction
Your input is important to us. Please complete this form to provide feedback related to the content on this product.
Product Title
Spot an opportunity for improvement?Share a Content Correction